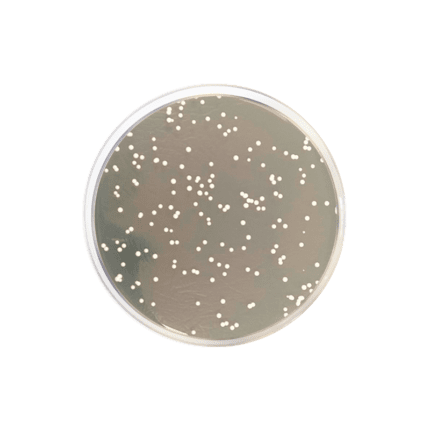
محیط کشت YGC, خرید محیط کشت YGC, فروش محیط کشت YGC , 116000  , Yeast Glucose Chloramphenicol Agar

محیط کشت EC
فروش محیط کشت EC (نام کامل: Escherichia coli Broth ) با کد 110765 برند مرک اصل با کیفیتی تضمینی در آرمان کیمیا زیست، تامین کننده مواد شیمیایی آزمایشگاهی با بیش از ۳۰ سال سابقه، جهت خرید محیط کشت EC با ما تماس بگیرید یا شماره تماس خود را وارد نمائید تا کارشناسان فروش در اسرع وقت با شما تماس بگیرند
جدول خصوصیات محلول
| pH |
6.7 – 7.1 (37 g/l, H₂O, 25 °C) (after autoclaving) |
|---|---|
| حجم | , |
| کد محصول | , |
| کمپانی سازنده |
سیگما الدریچ (Sigma-Aldrich) ,مرک (Merck) |
| کشور سازنده |
آلمان |
محیط کشت EC (Escherichia coli) چیست؟
محیط کشت ای سی براث به انگلیسی : EC (Escherichia coli) Broth یکی از محصولات با کیفیت و ضروری در آزمایشگاههای میکروبیولوژی است که برای کشت و شناسایی باکتری اشریشیا کلی مورد استفاده قرار میگیرد. این محیط کشت با ترکیبی بهینه از مواد مغذی و عوامل انتخابی تهیه شده است که شرایط مطلوب برای رشد و تکثیر این باکتری را فراهم میکند.
ویژگیهای فیزیکوشیمیایی
محیط کشت ای سی براث دارای خصوصیات فیزیکوشیمیایی زیر است:
- pH: حدود ۶.۹ تا ۷.۳ در دمای ۲۵ درجه سانتیگراد
- شکل ظاهری: پودر زرد کمرنگ تا قهوهای که پس از حل شدن در آب مقطر، محلول شفاف زرد رنگ ایجاد میکند.
- ترکیبات: شامل پپتون، لاکتوز، نمک صفراوی و دیگر مواد مغذی مورد نیاز برای رشد بهینه باکتری.
کاربردها
این محیط کشت در شناسایی و شمارش باکتری اشریشیا کلی از نمونههای غذایی، آب، و سایر نمونههای محیطی کاربرد دارد. همچنین در آزمایشگاههای تحقیقاتی و تشخیصی برای تعیین وجود و میزان آلودگی با این باکتری مورد استفاده قرار میگیرد. به دلیل دقت و کارایی بالا، این محصول انتخابی ایدهآل برای آزمایشگاههایی است که به دنبال نتایج قابل اعتماد و دقیق هستند.
حجمها و بستهبندی
محیط کشت ای سی براث در بستهبندیهای متنوعی عرضه میشود که شامل حجمهای مختلف برای نیازهای گوناگون آزمایشگاهی است. این محصول به صورت پودر در بستهبندیهای ۵۰۰ گرمی، ۱۰۰۰ گرمی و بستههای بزرگتر قابل تهیه است که به کاربران امکان میدهد با توجه به نیاز خود حجم مناسبی را انتخاب کنند.
نحوه استفاده
برای آمادهسازی محیط کشت، مقدار مشخصی از پودر را در آب مقطر حل کرده و پس از اتوکلاو کردن، آن را در پتری دیشها یا لولههای آزمایش ریخته و نمونههای مورد نظر را کشت میدهند. شرایط دمایی و مدت زمان کشت باید طبق دستورالعملهای استاندارد رعایت شود تا بهترین نتایج به دست آید.
با خرید این محیط کشت از مرک، از کیفیت بالای محصول و اطمینان از دقت و صحت نتایج آزمایشگاهی خود مطمئن باشید. این محصول به دلیل ویژگیهای منحصر به فرد خود، انتخابی مطمئن برای آزمایشگاههای حرفهای است.

مونا –
پاسخدهی سریع تیم پشتیبانی و ارسال بهموقع باعث شد خرید خیلی راحت باشه